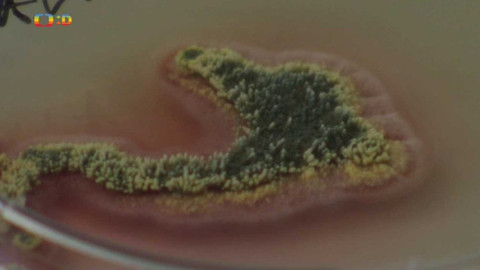
Zprávičky - 9. listopadu 2018

8. listopadu 2018
Obsah dílu
Úniková hra Osudové osmičky – Technické pomůcky pro zrakově postižené – Kvíz – Šachový zápas proti třiceti soupeřům
Přehled dílů

12. února
Dětský sbor Kajetán — Autistická dívka tančí navzdory svému handicapu — Fotbaloví fanoušci podpořili svůj tým v Turecku

11. února
Poslední regionální kolo ankety „Zlatý „Ámos“ — Žákům pomáhají školní poradny — Libeňská soutěž ve skákání přes švihadlo

10. února
Přihlášky na střední školy — V Dánsku plánují zavést malé třídy na I. stupni — Běžecký závod „Winter run“ v Ostravě

4. února
Výstavy ve Sladovně Písek — Dětská literární soutěž v Táboře — Hokejový zápas v Ledči nad Sázavou

3. února
Regionální kola ankety Zlatý Ámos 2026 — Mediální gramotnost školáků ve Finsku — Mistrovství světa v běhu s plážovým lehátkem

2. února
45 let Studia kamarád — 31. ročník Dětského karnevalu v Chorvatské Rijece — Úspěch českých juniorských tenistek na Australian Open

1. února
Víkendová akce „Ledová města“ — Muzeum vědy a techniky v Šanghaj — Závod Jizerská 50

31. ledna
Výsledky Minisčítání — Autobusová zastávka jako miniknihovna — Dětské závody Mini Jizerská

30. ledna
Téma týdne: První pololetí školního roku — Noc a den v DDM — Mládě kančila jávského — Planeta Liga

29. ledna
Pololetní vysvědčení v Otvovicích — Devade, výstava v centru architektury — Ledové sochy pro olympiádu — Olympijský trénink na ZŠ Mariánské náměstí



